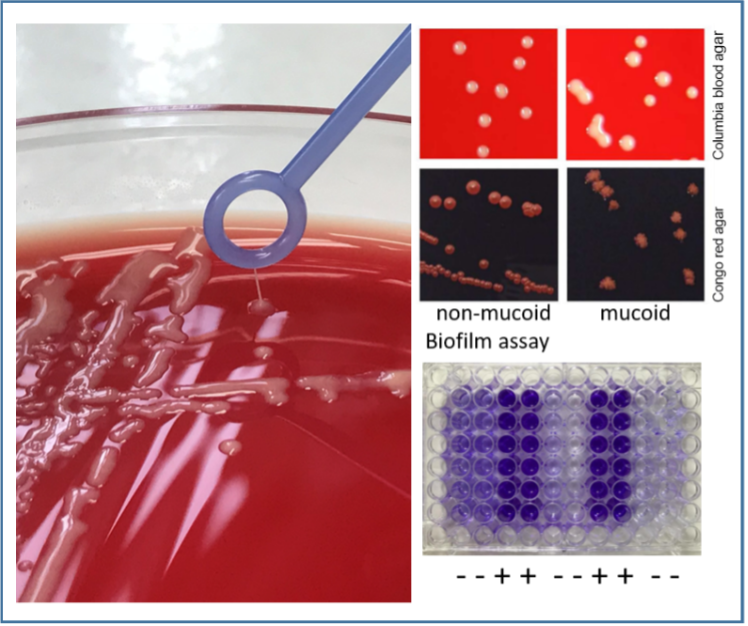

Mukoide Staphylococcus aureus-Isolate bei der chronischen Atemwegsinfektion bei Mukoviszidose
Charakterisierung mukoider Staphylococcus aureus Isolate, die aus den Atemwegen von Mukoviszidose Patienten isoliert wurden: Prävalenz, klinische Bedeutung und detaillierte Analyse mittels molekularer und Bildgebungsverfahren.
In einer multizentrischen Studie, an der 13 Zentren mit über 600 Personen mit Mukoviszidose teilnehmen (PmCF), weisen wir die Prävalenz der bisher wenig beobachteten mukoiden S. aureus-Isolate nach, untersuchen den zu Grunde liegenden Machanismus und analysieren eine mögliche Assoziation zum klinischen Krankheitsbild.
Das Projekt wird durch die DFG gefördert (KA 2249/5-1; 2018-2023)
Die Interaktion von Staphylococcus aureus und Pseudomonas aeruginosa
Die Interaktion von Staphylococcus aureus und Pseudomonas aeruginosa bei chronischen Atemwegsinfektionen von Patienten/Personen mit Mukoviszidose (CF), primärer ciliärer Dyskinesie (PCD) und chronischer Tracheostomie (CTT).
In diesem Projekt untersuchen wir die Interaktion von S. aureus und P. aeruginosa, die kompetitiv (die Erreger inhibieren sich) oder kommensal (beide Erreger überleben) ausfallen können. Beide Erreger treten häufig bei chronischen Atemwegsinfektionen bei CF, PCD und CTT gleichzeitig auf. In einer prospektiven Observationsstudie soll untersucht werden, ob die spezifische Interaktion der Erreger einen Einfluss auf den Verlauf der Lungenerkrankung hat.
Das Projekt wurd durch die Innovative Medizinische Forschung (IMF DA12 22 06) gefördert - (2023-2026).